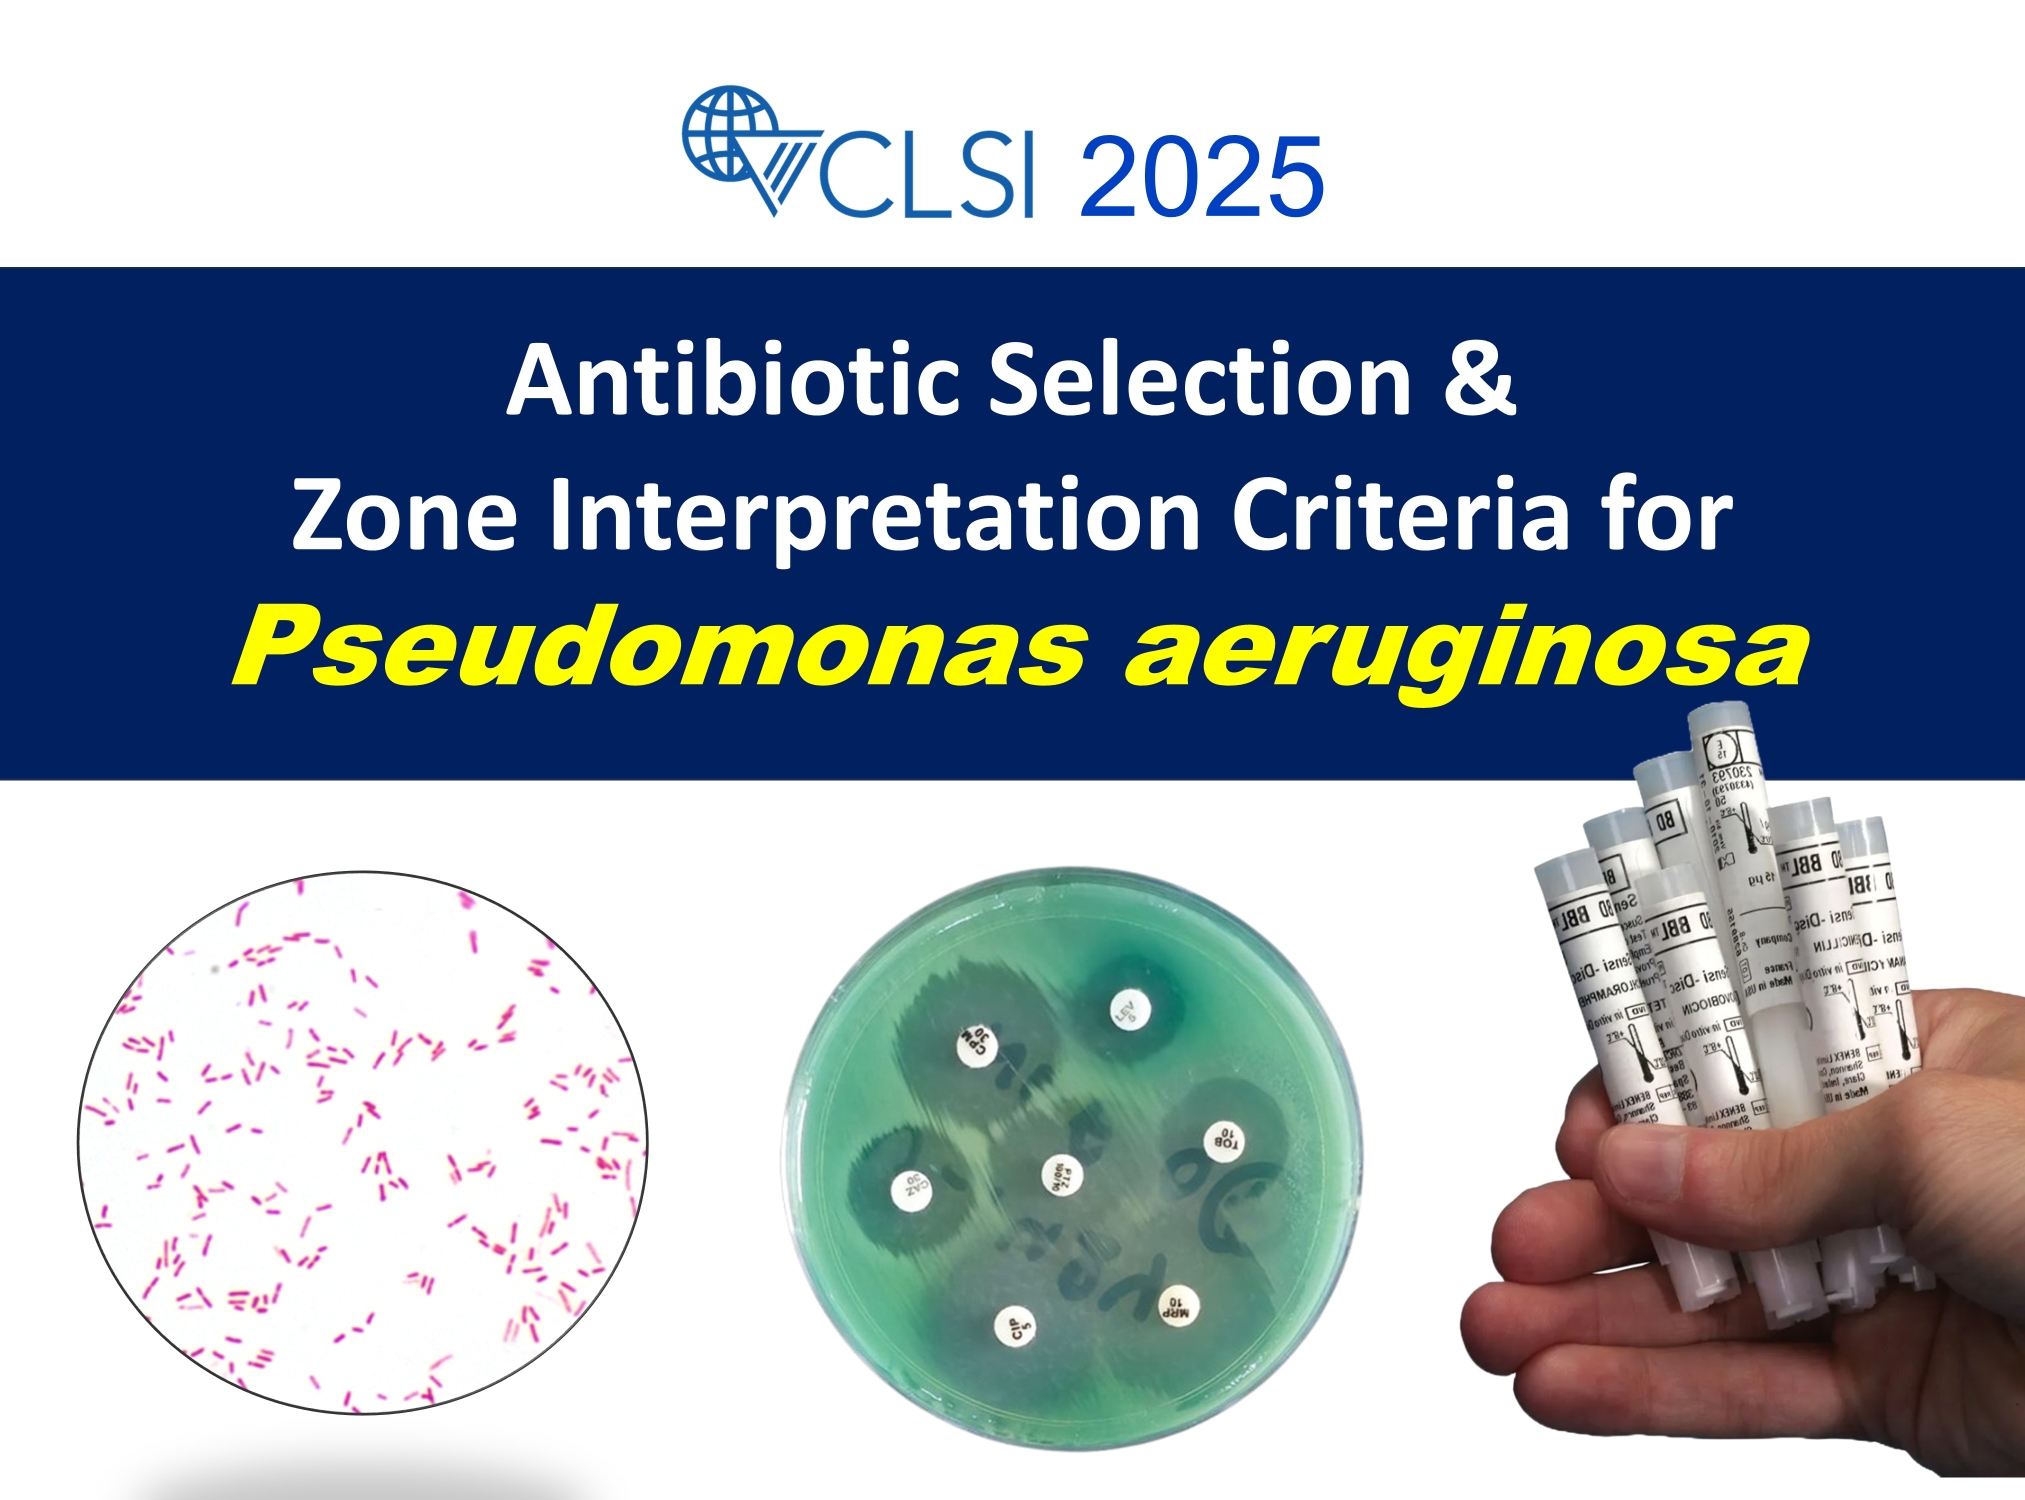
CLSI-2025-Pseudomonas-aeruginosa

Antimicrobial susceptibility testing (AST) measures an antimicrobial agent’s ability to inhibit the growth of a microorganism. Several AST methods are available to determine bacterial susceptibility to antimicrobials. The disk diffusion method is an inexpensive and very common method.
AST is carried out using standardized laboratory methods and is interpreted according to guidelines established by organizations such as the Clinical and Laboratory Standards Institute (CLSI) and the European Committee on Antimicrobial Susceptibility Testing (EUCAST).
Breakpoints are MIC values or zone diameters that classify an organism as susceptible (S), intermediate (I), or resistant (R) to a specific antimicrobial agent. Breakpoints vary not only according to the antimicrobial but also to the organism. This document summarizes the updated zone diameter breakpoints and interpretation criteria for Pseudomonas aeruginosa in the disk diffusion method as published in the CLSI M100, Performance Standards for Antimicrobial Susceptibility Testing, 35th Edition (2025).
CLSI 2025 Breakpoints for Pseudomonas aeruginosa
The following table lists the CLSI 2025 zone diameter breakpoints for Pseudomonas aeruginosa. All values represent zones of inhibition (ZOI) measured in millimeters (mm).
| Tier | Antimicrobial agent | Sensitive | Intermediate | Resistant | Remarks |
|---|---|---|---|---|---|
| 1 | Cefepime (30 µg) | ≥18 | 15-17 | ≤14 | |
| 1 | Ceftazidime (30 µg) | ≥18 | 15-17 | ≤14 | |
| 1 | Ciprofloxacin (5 µg) | ≥25 | 19-24 | ≤18 | |
| 1 | Levofloxacin (5 µg) | ≥22 | 15-21 | ≤14 | |
| 1 | Piperacillin-tazobactam (100/10 µg) | ≥22 | 18-21 | ≤17 | |
| 1 | Tobramycin (10 µg) | ≥19 | 13-18 | ≤12 | |
| 2 | Amikacin | ≥17 | 15-16 | ≤14 | Urine only |
| 2 | Imipenem (10 µg) | ≥19 | 16-18 | ≤15 | |
| 2 | Meropenem (10 µg) | ≥19 | 16-18 | ≤15 | |
| 3 | Cefiderocol (30 µg) | ≥18 | 13–17 | ≤12 | |
| 3 | Ceftazidime-avibactam (30/20 µg) | ≥21 | – | ≤20 | |
| 3 | Ceftolozane-tazobactam (30/10 µg) | ≥21 | 17-20 | ≤16 | |
| 3 | Imipenem-relebactam (10/25 µg) | ≥23 | 20-22 | ≤19 | |
| 4 | Aztreonam (30 µg) | ≥22 | 16-21 | ≤15 | |
| Colistin/Polymyxin B | (MIC) | ||||
| Ofloxacin (5 µg) | ≥16 | 13-15 | ≤12 | ||
| Piperacillin (100 µg) | ≥22 | 18-21 | ≤17 | ||
Selection of Antibiotics for AST of Pseudomonas aeruginosa
- Tier 1: Appropriate for routine, primary testing and reporting.
- Tier 2: Appropriate for routine, primary testing. Reporting may follow institution-specific cascading rules.
- Tier 3: Introduced for institutions with high levels of multidrug-resistant organisms. Appropriate for routine, primary testing and reporting but must follow institution-specific cascade rules.
- Tier 4: Reserved for testing/reporting on request. Used if other antimicrobial agents in other tiers are not optimal because of various factors.
Testing conditions for Pseudomonas aeruginosa
- Medium: Muller Hinton Agar (MHA)
- Inoculum: Colony suspension, equivalent to a 0.5 McFarland standard
- Number of antibiotic discs: Maximum 12 discs on 150 mm plate, no more than 6 discs on 100 mm plate
- Distance between discs: Discs should be placed no less than 24 mm apart (center to center)
- Incubation: 35C±2°C, ambient air, 16-18 hours
Intrinsic Resistance of Pseudomonas aeruginosa
Pseudomonas aeruginosa (and all other non-lactose fermenting gram-negative bacteria) are intrinsically resistant to the following antibiotics:
- Penicillins
- First and second generation cephalosporins
- Clindamycin/Daptomycin
- Glycopeptides (vancomycin)
- Linezolid
- Macrolides (e.g., Erythromycin, Azithromycin)
- Quinupristin-dalfopristin
- Rifampin
In addition to above antibiotics, Pseudomonas aeruginosa also shows intrinsic resistance to the following antibiotics:
- Ceftriaxone, cefotaxime
- Amoxicillin-clavulanate, ampicillin-sulbactam
- Trimethoprim-sulfamethoxazole
- Tetracyclines
- Etrapenem
- Chloramphenicol
References
- CLSI. Performance Standards for Antimicrobial Susceptibility Testing. 35th ed. CLSI supplement M100. Clinical and Laboratory Standards Institute; 2025.
Be the first to comment